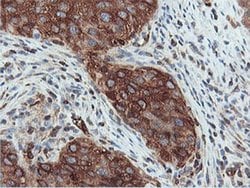
PFKP Monoclonal Antibody (OTI3A12), TrueMAB , OriGene 100 &mu;L; Unconjugated:Antibodies,

missing translation for 'onlineSavingsMsg'
Learn More
Learn More
PFKP Monoclonal Antibody (OTI3A12), TrueMAB™, OriGene
Mouse Monoclonal Antibody
Marca: Origene Technologies TA503980

Este artículo no se puede devolver.
Vea la política de devoluciones
Descripción
Protein kinases are enzymes that transfer a phosphate group from a phosphate donor, generally the g phosphate of ATP, onto an acceptor amino acid in a substrate protein. By this basic mechanism, protein kinases mediate most of the signal transduction in eukaryotic cells, regulating cellular metabolism, transcription, cell cycle progression, cytoskeletal rearrangement and cell movement, apoptosis, and differentiation. With more than 500 gene products, the protein kinase family is one of the largest families of proteins in eukaryotes. The family has been classified in 8 major groups based on sequence comparison of their tyrosine (PTK) or serine/threonine (STK) kinase catalytic domains. The AGC kinase group consists of 63 kinases including the cyclic nucleotide-regulated protein kinase (PKA & PKG) family, the diacylglycerol-activated/phospholipid-dependent protein kinase C (PKC) family, the related to PKA and PKC (RAC/Akt) protein kinase family, the kinases that phosphorylate G protein-coupled receptors family (ARK), and the kinases that phosphorylate ribosomal protein S6 family (RSK).Especificaciones
| PFKP | |
| Monoclonal | |
| 0.61 mg/mL | |
| PBS with 1% BSA, 50% glycerol and 0.02% sodium azide | |
| Q01813 | |
| PFKP | |
| Full length human recombit protein of human PFKP produced in HEK293T cell. | |
| 100 μL | |
| Primary | |
| Human | |
| Antibody | |
| IgG1 |
| Flow Cytometry, Immunocytochemistry, Immunofluorescence, Immunohistochemistry (Paraffin), Western Blot | |
| OTI3A12 | |
| Unconjugated | |
| PFKP | |
| ATP-PFK, PFK-C, PFK-P, PFKF | |
| Mouse | |
| Affinity Chromatography | |
| RUO | |
| 5214 | |
| -20° C, Avoid Freeze/Thaw Cycles | |
| Liquid |
Corrección del contenido de un producto
El Programa Encompass de Fisher Scientific ofrece artículos que no forman parte de nuestra cartera de distribución. Estos productos no suelen tener imágenes ni descripciones detalladas. Sin embargo, nos comprometemos a mejorar su experiencia de compra. Utilice el siguiente formulario para hacernos llegar sus comentarios sobre el contenido de este producto.
Título del producto
¿Detecta una oportunidad de mejora?Comparta una corrección de contenido